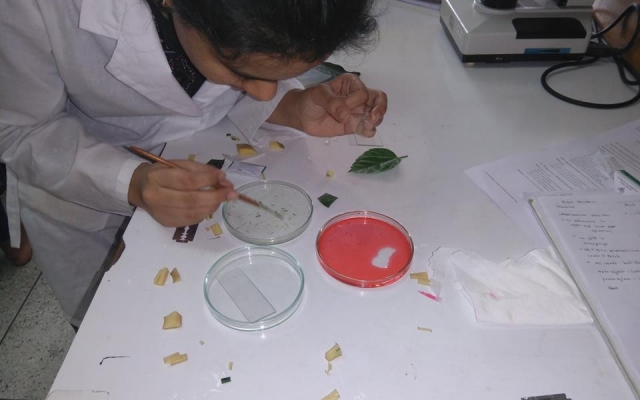

Duration: 23 March (08:00 AM) – 26 March (12:00 PM)
Venue: National Institute of Biotechnology, Savar
Memories of the Fourth NMST National BioCamp 2018
Master Campers of the Fourth NMST National BioCamp 2018
More pics of BioCamp are available here and here
Result of the Fourth NMST National BioCamp 2018
Note: Following list of campers is based on performance in both NMST National Biology Olympiad – 2018 MCQ Examination and Camp Pre-selection Examination – 2018. Also, this list comprises of those students who actually confirmed their participation in BioCamp 2018. The score and status mentioned here is based on the objective structured practical examination (OSPE) taken at the BioCamp.
| Reg. No. | Name in English | Name in Bangla | Institute | Score (60) | Status |
| 14479 | MD. BAYEZID MIA | মোঃ বায়েজিদ মিয়া | INTERNATIONAL TURKISH HOPE SCHOOL | 49.45 | Master Camper |
| 1802302682 | PROKRITI PROJUKTI | প্রকৃতি প্রযুক্তি | VIQARUNNISA NOON SCHOOL AND COLLEGE | 48.25 | Master Camper |
| 1809200385 | RAAD SHARAR | রাদ শারার | RAJSHAHI COLLEGIATE SCHOOL | 48.00 | Master Camper |
| 1804300011 | MD TAMZID HOSSAIN TANIM | মোঃ তামজীদ হোসেন তানিম | GOVT. M M CITY COLLEGE, KHULNA | 47.25 | Master Camper |
| 1801501711 | RAFSAN RAHMAN RAAYAN | রাফসান রহমান রায়ান | THE AGA KHAN SCHOOL, DHAKA | 45.50 | Master Camper |
| 1802202418 | ABRAR TASNEEM ABIR | আবরার তাসনীম আবির | ST. GREGORY’S HIGH SCHOOL COLLEGE | 42.00 | Master Camper |
| 1809100135 | TASNIM AFIFA APOLA | তাসনিম আফিফা অপলা | PARAMOUNT SCHOOL & COLLEGE, RAJSHAHI | 41.70 | Master Camper |
| 1801508733 | AUDDITHIO NAG | অদ্বিতীয় নাগ | SFX GREENHERALD INTERNATIONAL SCHOOL | 41.25 | Master Camper |
| 1810206842 | M. FARHAN ISHMAM | এম. ফারহান ইশমাম | K B HIGH SCHOOL | 39.50 | ___ |
| 1802602171 | PARMITA PROTIK DAS | পারমিতা প্রতিক দাশ | SUNNYDALE SCHOOL | 39.10 | ___ |
| 1801600499 | PRITAM KRISHNA KUNDU | প্রীতম কৃষ্ণ কুন্ড | MASTERMIND ENGLISH MEDIUM SCHOOL | 38.75 | ___ |
| 1801203379 | NURJAHAN ARA HOSSAIN | নূরজাহান আরা হোসাইন | IDEAL SCHOOL AND COLLEGE | 36.25 | ___ |
| 1802602782 | MAEESHA TASNIM NAOMI | মায়িশা তাসনিম নাওমি | SUNNYDALE | 35.00 | ___ |
| 1802502228 | MAHI AHMED | মাহি আহমেদ | SCHOLARS’ SCHOOL AND COLLEGE | 34.50 | ___ |
| 1801508849 | WASI IQBAL | ওয়াসি ইকবাল | INTERNATIONAL TURKISH HOPE SCHOOL | 33.60 | ___ |
| 1806200098 | IBNUL MUHTADI SHAH | ইবনুল মুহ্তাদি শাহ | THE FLOWERS KG AND HIGH SCHOOL | 31.65 | ___ |
| 1808104594 | S. M. NAYEEM | এস,এম,নাঈম | RDA LAB. SCHOOL AND COLLEGE, BOGRA | 30.50 | ___ |
| 1803108276 | TONMOY DEB BARMAN | তন্ময় দেব বর্মণ | AMENA-BAKI RESIDENTIAL MODEL SCHOOL | 24.70 | ___ |
| 1801601847 | SYED TAZMILUR RAHMAN SAAD | সৈয়দ তাজমিলুর রহমান সাদ | MANARAT DHAKA INTERNATIONAL SCHOOL AND COLLEGE | N/A | Absent |
Master Campers will be notified over phone about the next round of training and selection.